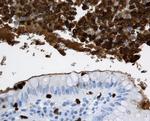
Calprotectin Antibody in Immunohistochemistry, Immunohistochemistry (Paraffin) (IHC, IHC (P))

Search
Invitrogen
Calprotectin Monoclonal Antibody (MAC387)
{{$productOrderCtrl.translations['antibody.pdp.commerceCard.promotion.promotions']}}
{{$productOrderCtrl.translations['antibody.pdp.commerceCard.promotion.viewpromo']}}
{{$productOrderCtrl.translations['antibody.pdp.commerceCard.promotion.promocode']}}: {{promo.promoCode}} {{promo.promoTitle}} {{promo.promoDescription}}. {{$productOrderCtrl.translations['antibody.pdp.commerceCard.promotion.learnmore']}}
产品信息
MA5-12213
已发表种属
宿主/亚型
分类
类型
克隆号
抗原
偶联物
形式
浓度
保存条件
运输条件
RRID
靶标信息
The S100A8/A9 heterocomplex, also called MRP-8/MRP-14 complex or calprotectin, comprises 60% of the cytoplasmic protein fraction of circulating polymorphonuclear granulocytes and is also found in monocytes, macrophages and ileal tissue eosinophils. Peripheral blood monocytes carry the antigen extra- and intracellularly, neutrophils only intracellularly. The S100A8/A9 complex has antibacterial, antifungal, immunomodulating and antiproliferative effects. Besides this it is a potent chemotactic factor for neutrophils. Plasma concentrations are elevated in diseases associated with increased neutrophil activity, like inflammatory bowel disease. Granulocytes terminate their existence after transmigration through the intestinal wall. Therefore calprotectin is also detectable in feces. Elevated levels of calprotectin have been observed in body fluids such as plasma, saliva, gingival crevicular fluid, stools, and synovial fluid during infection and inflammatory conditions.
仅用于科研。不用于诊断过程。未经明确授权不得转售。